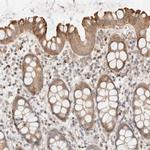
FAT1 Antibody in Immunohistochemistry (IHC)

Search
Invitrogen
FAT1 Polyclonal Antibody
{{$productOrderCtrl.translations['antibody.pdp.commerceCard.promotion.promotions']}}
{{$productOrderCtrl.translations['antibody.pdp.commerceCard.promotion.viewpromo']}}
{{$productOrderCtrl.translations['antibody.pdp.commerceCard.promotion.promocode']}}: {{promo.promoCode}} {{promo.promoTitle}} {{promo.promoDescription}}. {{$productOrderCtrl.translations['antibody.pdp.commerceCard.promotion.learnmore']}}
产品信息
PA5-54910
种属反应
宿主/亚型
分类
类型
抗原
偶联物
形式
浓度
规格
纯化类型
保存液
内含物
保存条件
运输条件
RRID
产品详细信息
Immunogen sequence: NFQRALRNIL GVRRNDIQIV SLQSSEPHPH LDVLLFVEKP GSAQISTKQL LHKINSSVTD IEEIIGVRIL NVFQKLCAGL DCPWKFCDEK VSVDESVMST HSTARLSFVT PRHHRAAVCL CKEGRCP
Highest antigen sequence identity to the following orthologs: Mouse - 88%, Rat - 90%.
靶标信息
This gene is an ortholog of the Drosophila fat gene, which encodes a tumor suppressor essential for controlling cell proliferation during Drosophila development. The gene product is a member of the cadherin superfamily, a group of integral membrane proteins characterized by the presence of cadherin-type repeats. In addition to containing 34 tandem cadherin-type repeats, the gene product has five epidermal growth factor (EGF)-like repeats and one laminin A-G domain. This gene is expressed at high levels in a number of fetal epithelia. Its product probably functions as an adhesion molecule and/or signaling receptor, and is likely to be important in developmental processes and cell communication. Transcript variants derived from alternative splicing and/or alternative promoter usage exist, but they have not been fully described.
仅用于科研。不用于诊断过程。未经明确授权不得转售。
篇参考文献 (0)
生物信息学
蛋白别名: Cadherin family member 7; cadherin ME5; cadherin-related family member 8; Cadherin-related tumor suppressor homolog; FAT tumor suppressor 1; Protein fat homolog; Protocadherin Fat 1
基因别名: CDHF7; CDHR8; FAT; FAT1; hFat1; ME5
UniProt ID: (Human) Q14517
Entrez Gene ID: (Human) 2195